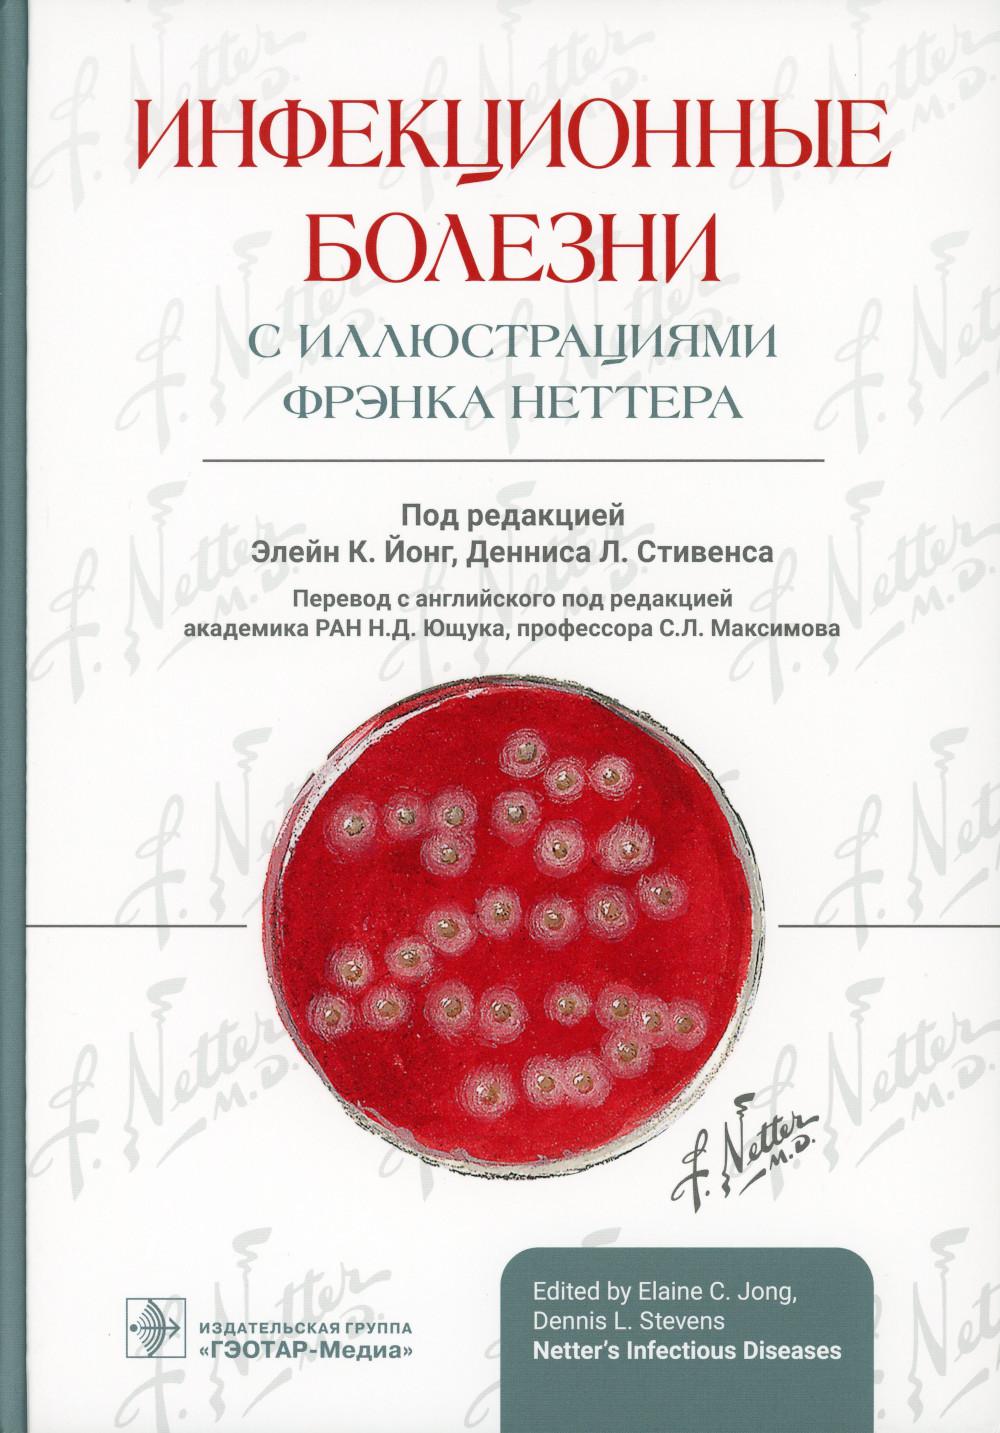
Инфекционные болезни с иллюстрациями Фрэнка Неттера / под ред. Э. К. Йонг, Д. Л. Стивенса ; пер. с англ. под ред. Н. Д. Ющука, С. Л. Максимова. — Москва : ГЭОТАР-Медиа, 2023. — 728 с. : ил.

1
/
of
1
ГЭОТАР-Медиа
Инфекционные болезни с иллюстрациями Фрэнка Неттера / под ред. Э. К. Йонг, Д. Л. Стивенса ; пер. с англ. под ред. Н. Д. Ющука, С. Л. Максимова. — Москва : ГЭОТАР-Медиа, 2023. — 728 с. : ил.
Инфекционные болезни с иллюстрациями Фрэнка Неттера / под ред. Э. К. Йонг, Д. Л. Стивенса ; пер. с англ. под ред. Н. Д. Ющука, С. Л. Максимова. — Москва : ГЭОТАР-Медиа, 2023. — 728 с. : ил.
Regular price
$188.49 USD
Regular price
Sale price
$188.49 USD
Unit price
/
per
Shipping calculated at checkout.
Couldn't load pickup availability
Product details
- Authors :
- Binding : Hardcover
- Coverage : 1000
- Ean : 9785970477892
- Format : 60x90/8
- Handling Time : 19 days
- Isbn : 978-5-9704-7789-2
- Pages : 728
- Publication Year : 2023
- Publisher :
В руководстве представлен краткий и вместе с тем подробный обзор современных глобальных проблем, связанных с инфекционными заболеваниями. Авторы раскрывают основы этой области медицины, используя для визуализации замечательные иллюстрации Фрэнка Неттера. В доступной форме приведена информация о наиболее часто встречающихся состояниях и проблемах, включая болезни, поддающиеся вакцинопрофилактике, устойчивые к лекарствам стафилококковые инфекции и туберкулез, грипп, эхинококкоз и болезнь Шагаса.Эта книга станет отличным инструментом для того, чтобы быстро ознакомиться с материалом, освежить свои знания и поделиться ими с пациентами и коллегами.Издание будет полезно как практикующим врачам-инфекционистам, так и врачам смежных специальностей, ординаторам и студентам.
Share


Isbn:
978-5-9704-7789-2
Ean:
9785970477892
HandlingTime:
19 days
Publisher:
ГЭОТАР-Медиа
Binding:
Hardcover
Pages:
728
1
/
of
2
Ordered
Dec 21
Order Ready
Jan 09
Delivered
Jan 11 - Jan 17